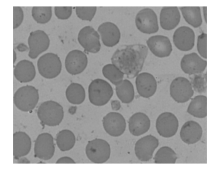

作者简介:范丽萍,女,1982年生,学士,技师,主要从事血液学检验工作。
LH750全自动血液分析仪是Beckman-Coulter公司生产的新型全自动五分类血液分析仪, 具有完善的计算分析系统。当血液样本中出现可疑的异常细胞时, 仪器内设定的警示系统可自动报警, 如异型淋巴细胞(Variant LY)、原始淋巴细胞(LY Blast)、原始单核细胞(Mo Blast)、原始中性粒细胞(NE Blast)、不成熟中性粒细胞1(Imm.NE1)(包括不成熟的中性粒细胞和/或中性杆状核粒细胞)、不成熟的中性粒细胞2(Imm.NE2)(包括早幼粒细胞、中幼粒细胞和晚幼粒细胞)及有核红细胞(NRBC)等信息。我们把这些可疑性报警提示设为中等(MED)敏感水平, 研究此设定水平下报警提示功能的可靠性。
1. 材料 (1)仪器:LH750全自动五分类血液分析仪(美国Beckman-Coulter公司生产); 光学显微镜(日本Olympus公司生产); (2)试剂:原装进口配套的稀释液、校准品和质控品(美国Beckman-Coulter公司生产)。瑞特染液(Baso染色液); (3)样本:456例经LH750全自动血液分析仪检测有异常细胞报警样本及300例无异常细胞报警的样本。
2. 方法 (1)每份送检的血常规样本按照仪器说明书进行检测; (2)将仪器显示有异常警示(Imm.NE1、Imm.NE2、NRBC、Blast、Variant LY)的样本进行手工涂片、瑞特染色并编号送检有形态学经验的技师进行盲片镜检; (3)镜检内容:在低倍镜或高倍镜下观察血片染色和细胞分布情况, 在涂片厚薄适中处切换至油镜, 仔细观察每一张血片的红细胞形态、白细胞形态及分类、血小板形态和有无NRBC、原始幼稚细胞和异型淋巴细胞等; (4)结果判断:镜检结果符合下列标准之一即判断为阳性, 中性杆状核细胞> 6%; 晚幼粒细胞或更早阶段的粒细胞> 1%; NRBC> 1%; 幼稚细胞> 1%; 异型淋巴细胞> 10%。
1.456例有异常细胞报警的样本(共出现536项报警)及300例无异常细胞报警的样本仪器法与手工显微镜法检测的结果见表1。仪器对异常细胞检出的灵敏度为97.9 %, 特异性为65.2%, 阳性预测值为70.1%, 阴性预测值为97.3%。
| 表1 756例样本仪器法和手工显微镜法检出异常细胞的结果 |
2.536项异常细胞报警信息中Imm.NE1、Imm.NE2、NRBC、Blast、Variant LY报警的分别有296、72、82、46、40项, 镜检阳性的分别为256、44、42、10、28项。756例样本中仪器阴性而镜检阳性的例数分别为4、4、10、0、2例。对各类异常细胞报警的灵敏度、特异性结果见表2。
| 表2 各类异常细胞报警的灵敏度及特异性分析(%) |
3. 在82例NRBC报警的样本中, 镜检阳性的仅为42例, 镜检阴性的样本中有12例观察到巨大血小板, 3例观察到小淋巴细胞。经观察发现巨大血小板和小淋巴细胞易误认为NRBC, 见图1和图2。
LH750全自动五分类血液分析仪采用Coulter 电阻抗原理和智能微数技术对血细胞进行计数, 基于VCS(细胞体积、高频传导、激光散射)技术, 结合更优化的计算软件系统对白细胞进行分类, 可提供31个血细胞分析参数和30多种怀疑/限定性旗标[1], 在其主机电脑屏幕上还提供了大量的警示信息, 如Flag直方图、散点图等。全自动血液分析仪对正常白细胞分类能力比肉眼分析要精确得多。但有异常细胞时, 仪器很难提供完全准确的分析结果[2]。因此检验人员应根据各种警示信息, 通过缩小目标, 进行显微镜复检。这样可大大降低手工强度, 提高工作效率。
本研究发现粒系的警示信息与镜检结果符合率较高。特别对仪器仅出现中性粒细胞左移警示, 白细胞轻、中度增高的样本, 仪器与手工镜检结果基本符合, 在制定实验室复检规则时可以放宽要求, 我们认为白细胞在18× 109/L以内未提示Blast, 嗜酸、嗜碱性粒细胞不增高时, 可以将仪器的左移信息提示给临床。经验丰富的检验者可根据警示信息和散点图来确定报告左移情况还是细分幼稚粒细胞百分比。仪器对NRBC的报警, 灵敏度为80.8%, 符合率为51.2%, 假阳性率较高, 假阴性也存在。在仪器有NRBC提示但镜检阴性的样本中, 常伴随着巨大血小板、小淋巴细胞或红细胞碎片, 其假阳性可能受巨大血小板、小淋巴细胞或红细胞碎片等的影响。在10例NRBC假阴性的样本中, 大多伴随着Giant Platelets、Platelet Clumps等红色警示信息或散点图的异常, 我们推测仪器有可能将NRBC误认为巨大血小板等。但镜检有NRBC的样本其白细胞直方图50 fL左侧可出现一个异常小峰, 检验者可根据Flag红色警示信息、直方图、临床诊断及血象情况来决定是否进行涂片镜检。外周血出现NRBC临床意义较大, 应注意避免漏检。我们建议仪器出现NRBC、Giant Platelets、Platelet Clumps警示信息均应仔细观察血涂片。仪器对Blast警示的灵敏度较高, 为100%。但对出现Blast警示的样本, 仪器结果与镜检结果存在着一定的差异, 符合率仅为21.7%。可能是由于药物或其他因素的影响, 使细胞形态发生改变, 导致仪器无法正确识别, 其具体机制有待进一步研究。由于Blast的临床意义较大, 对仪器提示Blast的样本, 均应人工复检。异型淋巴细胞的仪器警示信息与镜检结果的符合率为70%。经观察发现, 仪器将大多数形态不规则难于归类的细胞划分为异型淋巴细胞, 且涂片镜检阴性的样本大多单核和淋巴细胞比例增高。假阳性的原因也可能是仪器不能准确将异型淋巴与单核及大淋巴或小淋巴细胞区别开来, 假阴性的原因可能是仪器对数量较少的异型淋巴细胞不能准确识别。
本研究表明, LH750全自动五分类血液分析仪虽能对异常细胞报警, 但存在一定的假阳性与假阴性。在使用自动化血液分析仪检测血样本的同时, 辅之手工涂片镜检, 可以提高检验结果的准确性。尤其对血液系统疾病的筛查和诊断, 手工涂片镜检显得更加重要。然而手工涂片镜检操作烦琐, 工作量大。有专家在论述血片复查标准时建议, 每个实验室应自行规定复查条件, 这反映了当前国外较普遍的看法[3]。国际血液学会(ISLH)提出, 在保证血细胞分析仪质量的前提下, 应尽量减少涂片检查的样本数量[4]。根据血液分析仪的异常提示, 有选择针对性地进行涂片观察, 也是ISLH的建议之一。所以, 熟悉血液分析仪的性能, 尤其是异常细胞提示信息的可靠性, 就显得尤为重要。
The authors have declared that no competing interests exist.
| [1] |
|
| [2] |
|
| [3] |
|
| [4] |
|